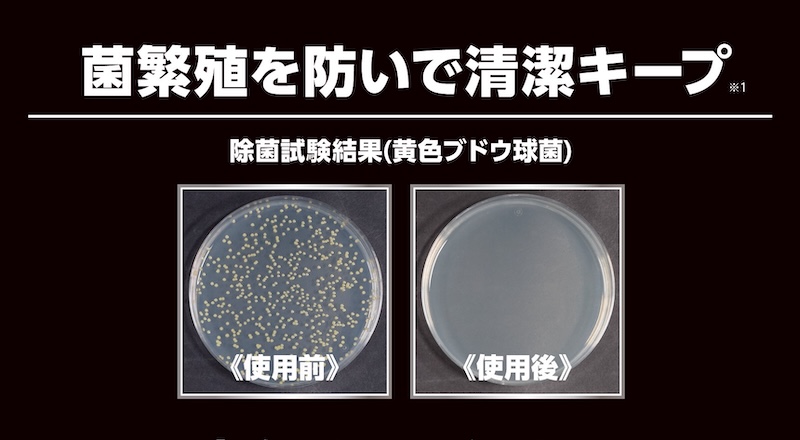
OLEFIRST_Mu-shu_powder｜２りんかん

洗っても、消臭ケアしても、新しい靴でされもすぐに臭わせてしまう俺!「臭う自分」を諦める前に。靴に振りかけて履くだけで臭わない俺に。辿りついた“粉の消臭力”(※1)
※1 全てのニオイに効果があるわけではありません。

長時間靴を履いてムレてニオう…
靴を洗ってもニオイが取れない…
そんなお悩み、実は“足”ではなく“靴”が原因かもしれません。

「OLE FIRST(オレファースト) 消臭パウダー Mu-shu」は、靴にサッと振りかけるだけで、ニオイの元となる雑菌を除菌※1し、消臭※1してくれるアイテムです。
主成分の天然ホタテパウダー※3が汗と反応して強力なアルカリ性になり、靴の中の雑菌を除菌して消臭(※1)!洗っても取れなかったニオイも、履きながらケアすることができます。

靴の嫌なニオイである「イソ吉草酸」、「酢酸」、「アンモニア」の三大悪臭にアタック(※1)。特に、足の納豆のようなニオイ物質の「イソ吉草酸」と、酸っぱいニオイ物質「酢酸」は99%消臭(※1)の実力!

粉は繊維内部に蓄積され、消臭効果が持続(※4)。使うほどニオわない靴に!
靴を履いている間に発生する蒸れは、雑菌の繁殖の原因になります。「OLE FIRST 消臭パウダー Mu-shu」は、そんな雑菌の繁殖を防ぎ※1、蒸れやすいブーツやスニーカーでも清潔な状態をキープしてくれます。

パンに「OLE FIRST消臭パウダーMu-shu」を半分かけて数日放置した画像。パウダーが汗や水分と反応すると、防カビ効果も発揮!食パンに「OLE FIRSTE 消臭パウダー Mu-shu」を付着した部分は、カビが増殖しませんでした。

靴だけでなく、汗でムレやすいグローブのアフターケアにも使える万能パウダーです。脱いだグローブの内側にパウダーを振りかけることで、 イヤなニオイを消臭・除菌・防カビ効果(※1)で、次回の着用時も清潔な状態で使用ができます。
※1 全てのニオイ、菌、カビに効果があるわけではございません。 ※3 貝殻焼成カルシウム ※4 パウダーが靴の中に留まっている間

OLEFIRST 無臭パウダーは、全国の2りんかんでお買い求めいただけます。
-
新製品
TAICHIから安全への新提案 ツーリング専用エアバッグ【T-SABE”ティーセーブ”】先行入荷
【ウェアメーカー”TAICHI”と四輪用エアバックシェア世界No.1の”オートリブ”との共… -
おすすめ


TAICHI プロテクターアップグレードキャンペーン開催!!
【ジャケットのプロテクターをお得にアップグレードできるキャンペーンが全店で開… -
新製品


RX-7X〈オグラ トラックハウス〉(OGURA TRACKHOUSE)プロショップ店舗にて予約受付開始!
Arai プロショップ限定でで予約受付中! 2026年日本人唯一のMotoGP最高峰クラスで… -
SALE


【厳選・店頭在庫限り】SHOEI Z-8専用設計インカム「SENA SRL-EXT」が特別価格!
【MESHインターコム対応のZ-8専用デザインモデルを、在庫限りのスペシャルプライス… -
SALE


【CARDO】高性能インカムGWキャンペーン開始
【高性能インカムが期間限定で驚きの20%OFFで販売!ゴールデンウィークに向けて準… -
SALE


通信機メーカーMIDLANDのR1 MESH 45%OFF ご要望にお応えして再入荷!数量限定販売中
【MIDLAND創業65年の通信技術が詰まったメッシュインカムをこの価格で体感できる最…










